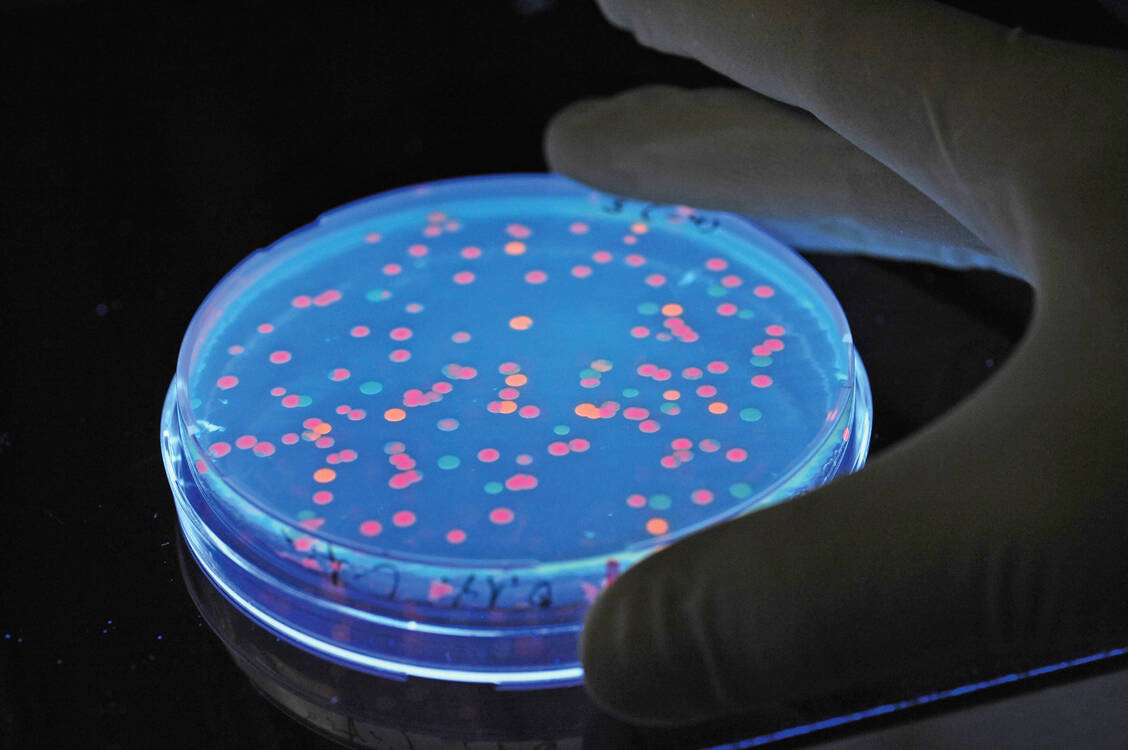

Weitere Angebote der PZ

© 2026 Avoxa - Mediengruppe Deutscher Apotheker GmbH